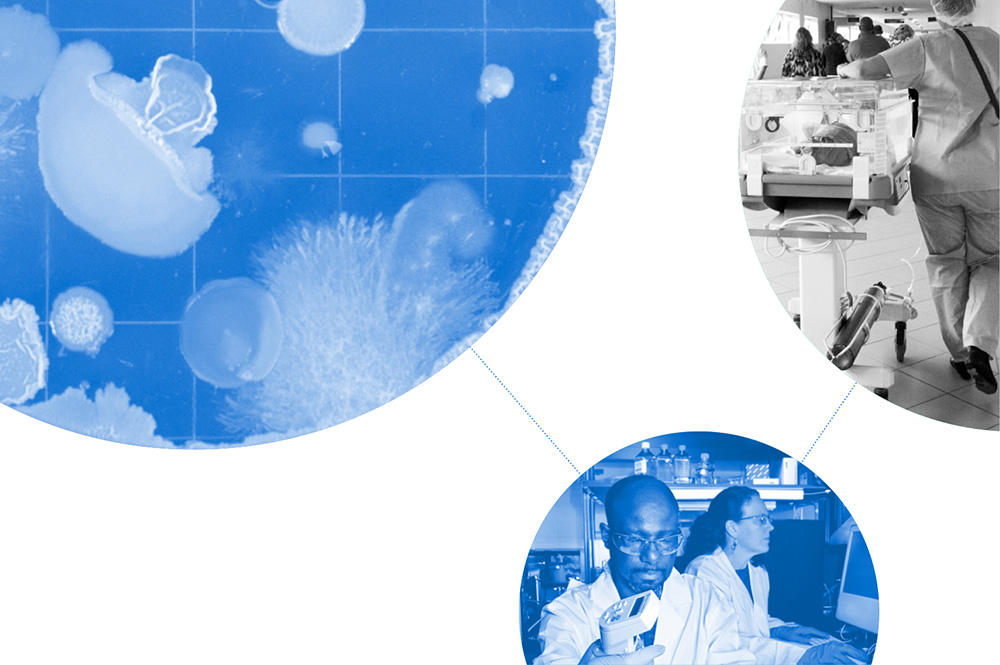
Q3-2024 Member Investor Portfolio Report

Catalyzing Innovation Through Information
Insights & Resources
Stay informed with up-to-date reports and data designed to provide a comprehensive view of Ohio’s life sciences ecosystem.
OLS Industry Economic Highlights
$0B
Total economic (output) impacts
$0B
Industry Wages & Benefits
$0B
R&D Activity
$0B
VC Funding to Life Sciences Companies (2019-2023)
Source: Ohio Life Sciences Industry, Assessment and Economic Impact Report, January 2025